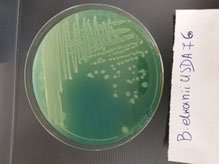
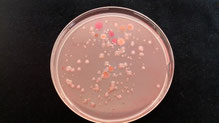

A very promising alternative farming system that is drawing more supporters is the combined use of legumes and rhizobia-based biofertilizers. However, with this approach, a number of questions are raised: Why are legumes so important in the context of sustainable agriculture? What are rhizobia and how are they related to legumes? What are biofertilizers and how do they benefit crop production?
Legumes are the key in organic farming which is an environment-friendly cultivation method, in contrast to conventional farming which is based on nitrogen fertilization. In legume roots, rhizobia form symbiotic relationships via nodule formation, contributing to the reduction of synthetic chemical inputs and greenhouse gas emissions due to biological nitrogen-fixation. Nodulation is a complex process, genetically controlled by both partners of the symbiotic relationship as well as by the environment through its influence on the activity of each partner and on the interaction itself.
Rhizobia are nitrogen-fixing soil bacteria that establish harsh competition with other indigenous soil bacteria to gain access to the roots and form nodules which are protective environments for them. Legume species differ greatly in their specificity for rhizobial symbionts. Legume plants select and shape their nodule symbionts by using an active recognition system that is genetically determined by both symbiotic partners. The environment and the peculiarities of a particular habitat such as climate and soil characteristics also affect legume-rhizobia symbiosis, resulting in the selection of rhizobial symbionts adapted to particular habitats. The metabolic activity of rhizobia (such as acid tolerance, drought/osmotic tolerance, antibiotics resistance), the ability of metabolizing specific substrates in combination with rhizobial adhesion to root surfaces are some critical points, which discriminate the most well adapted rhizobia in a particular habitat. Nodulation is energetically costly to legumes and they balance the benefit of acquiring fixed nitrogen with the energy expense by limiting the number of nodules through a systemic feedback inhibition signaling network called the autoregulation of nodulation.
For the successful implementation of TRUE Case studies 21 and 22 at the Agricultural University of Athens under WP2, isolation and characterization of rhizobia from nodules of various common bean varieties grown at different geographic locations of Greece will be performed. The genetic diversity of indigenous rhizobia will be assessed by applying DNA fingerprinting techniques. Representative isolates will be subjected to polyphasic characterization, in order to identify and determine their taxonomic position at species and symbiovar levels. In addition, the nodulation efficiency and competitiveness will also be evaluated. This research will enhance our knowledge on the phylogenetic diversity of indigenous bean-nodulating rhizobia in Greece and will contribute to select novel strains adapted to local environmental conditions and in other regions of the world with similar habitats. Therefore exploring rhizobial biodiversity, which is still unexploited, and the use of new strains that are best adapted to particular habitats and legume genotypes will contribute to the development of novel and more effective biofertilizers for the improvement of crop productivity with low environmental impact.
Authors:
Evdoxia Efstathiadou,
PhD Student
Anastasia Tampakaki, Ass. Professor
Dimitrios Savvas, Professor
Georgia Ntatsi, Researcher

Write a comment